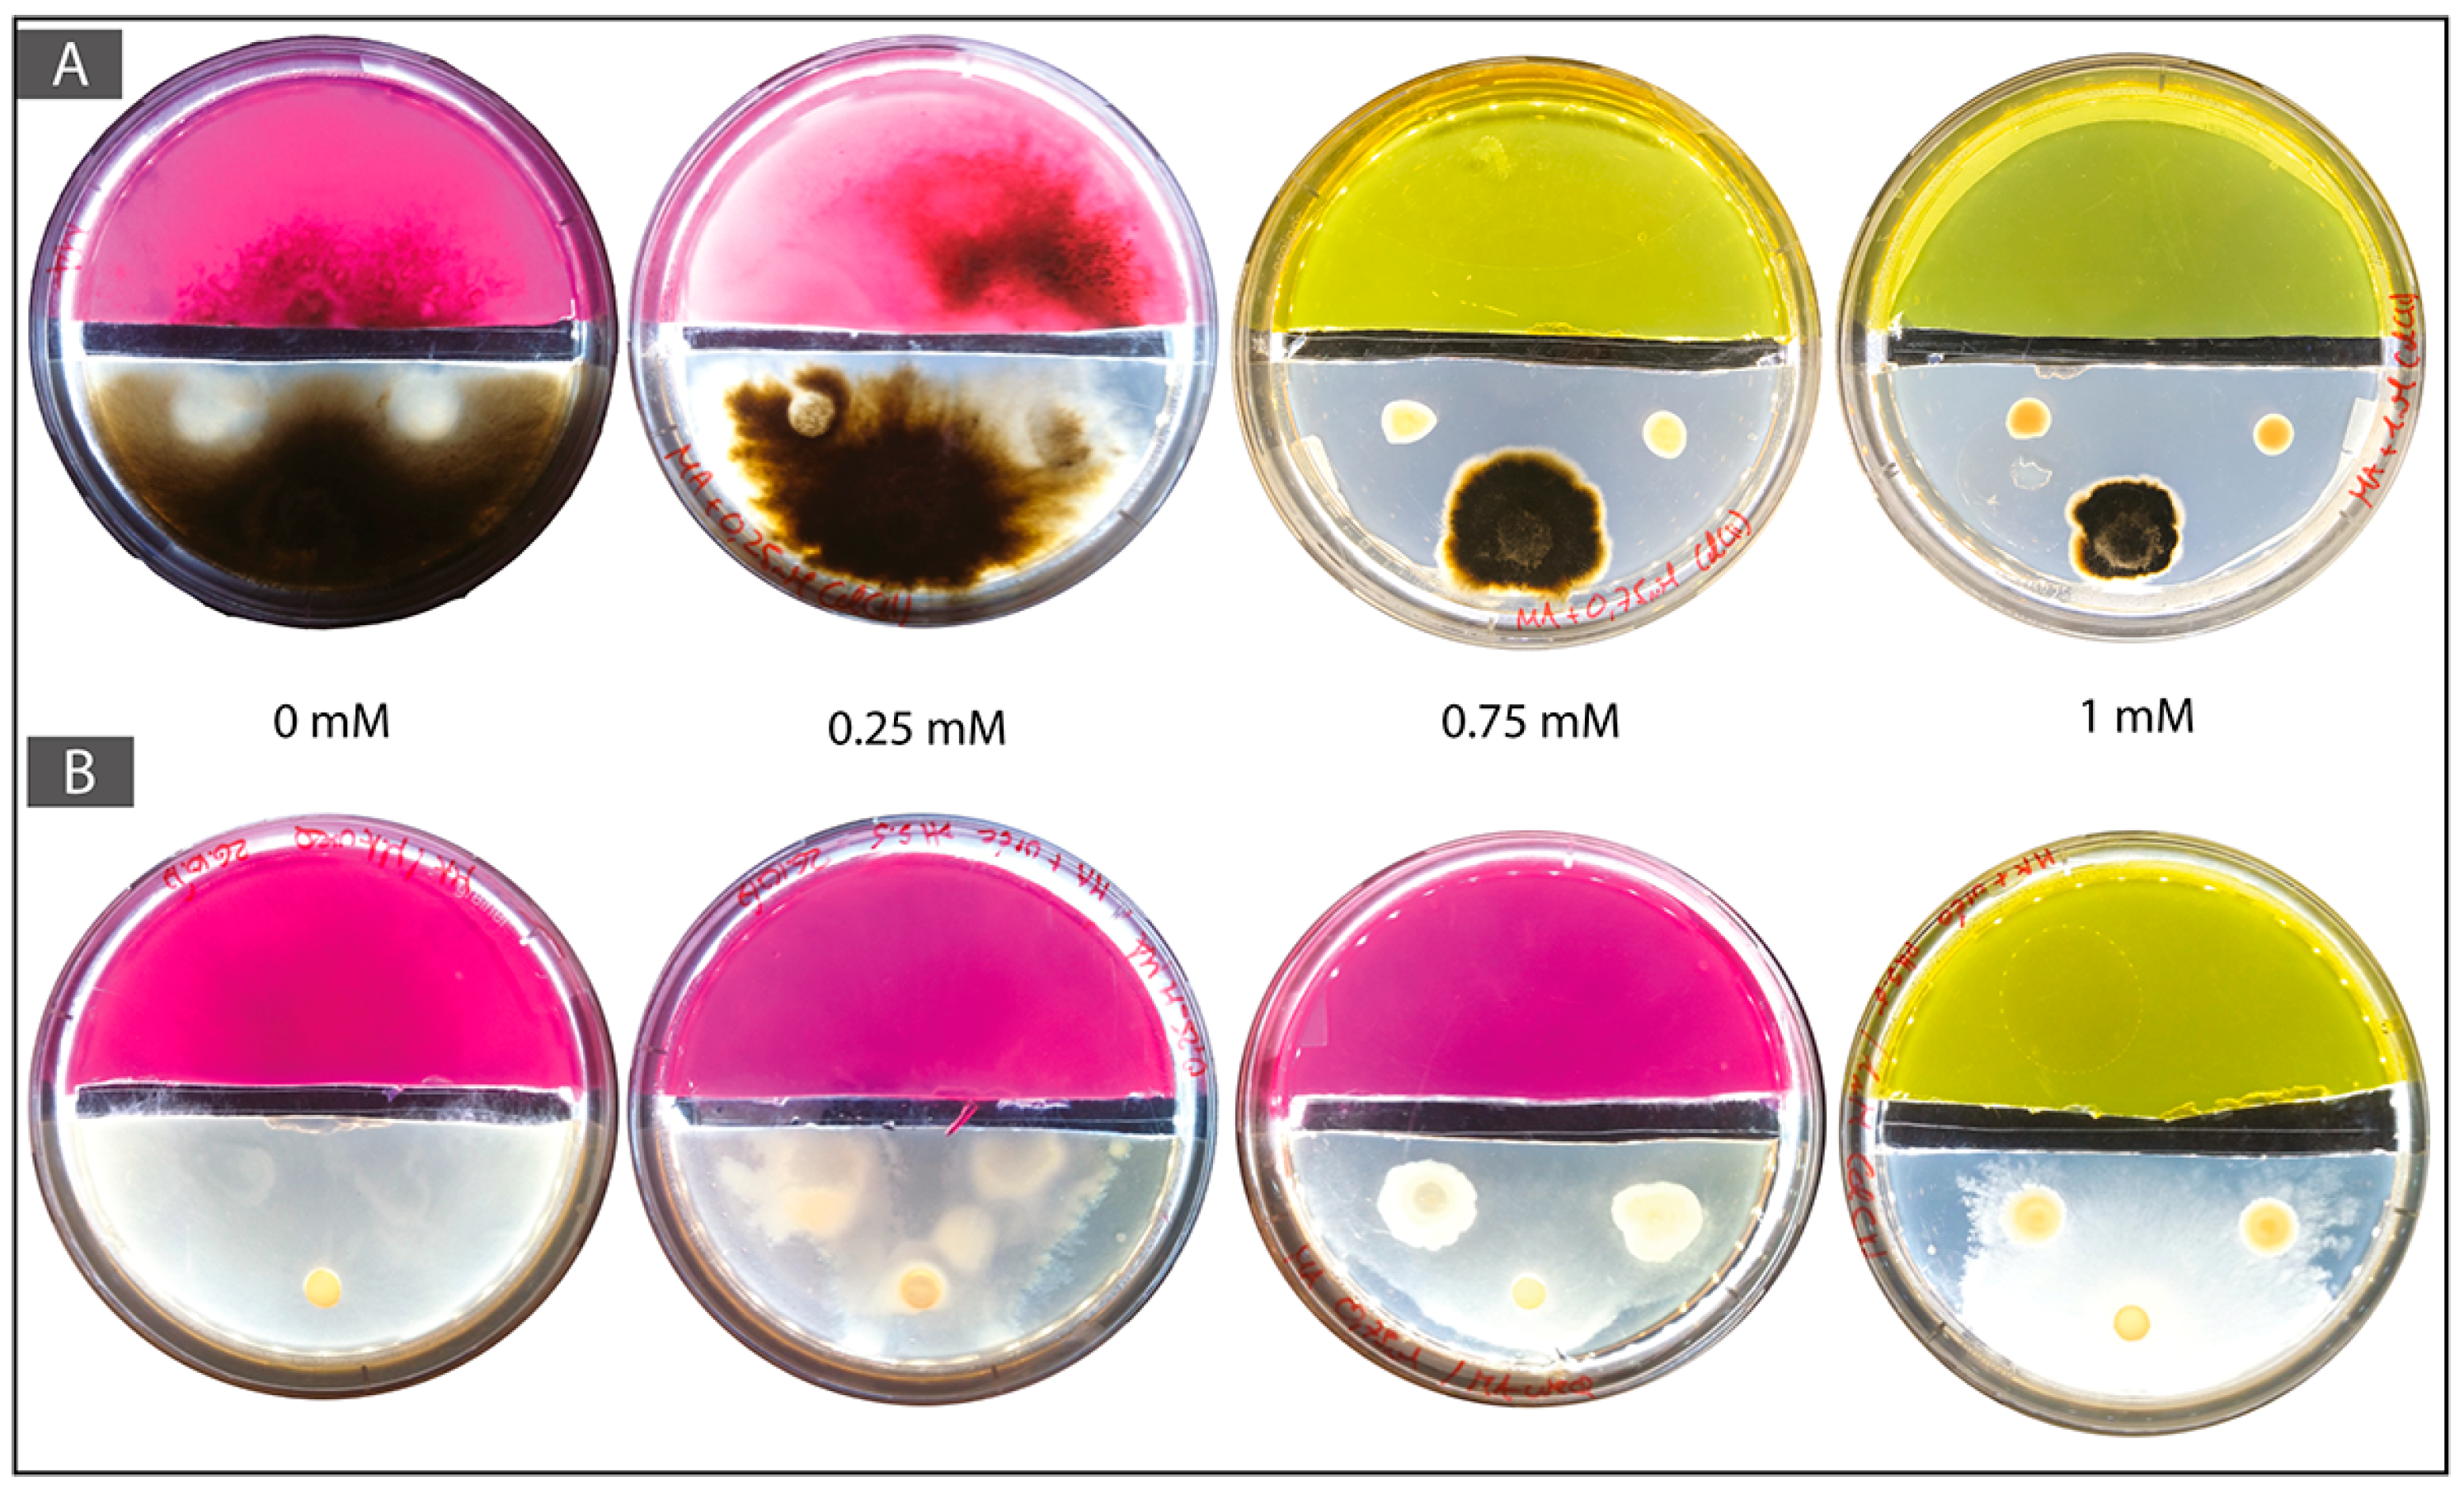

Enhanced Tolerance to Cadmium in Bacterial-Fungal Co-Cultures as a Strategy for Metal Biorecovery from e-Waste
Abstract
:1. Introduction
2. Materials and Methods
2.1. Field Sampling
2.2. Selection of Model Organisms
2.3. Selection of Cd Tolerant Synergistic Bacterial-Fungal Couples
2.4. Cadmium Mobilization Analysis
2.5. Cadmium Immobilization or Biomineralization
3. Results
3.1. Isolations of Bacterial and Fungal Strains from Cd Contaminated Soil
3.2. Selection from a Culture Collection
3.3. Biomass Assessments of the Synergistic BF Couples
3.4. Cadmium Mobilization Analysis
3.5. Two-Compartment Cd Mobilization and Immobilization Assay
4. Discussion
5. Conclusions
Acknowledgments
Author Contributions
Conflicts of Interest
Appendix A



References
- Robinson, B.H. E-waste: An assessment of global production and environmental impacts. Sci. Total Environ. 2009, 408, 183–191. [Google Scholar] [CrossRef] [PubMed]
- Cui, J.; Zhang, L. Metallurgical recovery of metals from electronic waste: A review. J. Hazard. Mater. 2008, 158, 228–256. [Google Scholar] [CrossRef] [PubMed]
- Widmer, R.; Oswald-Krapf, H.; Sinha-Khetriwal, D.; Schnellmann, M.; Böni, H. Global perspectives on e-waste. Environ. Impact Assess. Rev. 2005, 25, 436–458. [Google Scholar] [CrossRef]
- Balde, C.P.; Wang, F.; Kuehr, R.; Huisman, J. The Global e-Waste Monitor 2014: Quantities, Flows and Resources; United Nations University: Tokyo, Japan, 2015; ISBN 978-92-808-4555-6. [Google Scholar]
- Grant, K.; Goldizen, F.C.; Sly, P.D.; Brune, M.-N.; Neira, M.; van den Berg, M.; Norman, R.E. Health consequences of exposure to e-waste: A systematic review. Lancet Glob. Health 2013, 1, e350–e361. [Google Scholar] [CrossRef]
- Lin, C.; Wen, L.; Tsai, Y. Applying decision-making tools to national e-waste recycling policy: An example of Analytic Hierarchy Process. Waste Manag. 2010, 30, 863–869. [Google Scholar] [CrossRef] [PubMed]
- Cossu, R.; Williams, I.D. Urban mining: Concepts, terminology, challenges. Waste Manag. 2015, 45, 1–3. [Google Scholar] [CrossRef] [PubMed]
- Zhuang, W.-Q.; Fitts, J.P.; Ajo-Franklin, C.M.; Maes, S.; Alvarez-Cohen, L.; Hennebel, T. Recovery of critical metals using biometallurgy. Curr. Opin. Biotechnol. 2015, 33, 327–335. [Google Scholar] [CrossRef] [PubMed]
- Rawlings, D.E. Heavy Metal Mining Using Microbes. Annu. Rev. Microbiol. 2002, 56, 65–91. [Google Scholar] [CrossRef] [PubMed]
- Harms, H.; Schlosser, D.; Wick, L.Y. Untapped potential: Exploiting fungi in bioremediation of hazardous chemicals. Nat. Rev. Microbiol. 2011, 9, 177–192. [Google Scholar] [CrossRef] [PubMed]
- Gadd, G.M. Metals, minerals and microbes: Geomicrobiology and bioremediation. Microbiology 2010, 156, 609–643. [Google Scholar] [CrossRef] [PubMed]
- Gadd, G.M. Geomycology: Biogeochemical transformations of rocks, minerals, metals and radionuclides by fungi, bioweathering and bioremediation. Mycol. Res. 2007, 111, 3–49. [Google Scholar] [CrossRef] [PubMed]
- Nies, D.H. Efflux-mediated heavy metal resistance in prokaryotes. FEMS Microbiol. Rev. 2003, 27, 313–339. [Google Scholar] [CrossRef]
- Gadd, G.M.; Griffiths, A.J. Microorganisms and heavy metal toxicity. Microb. Ecol. 1977, 4, 303–317. [Google Scholar] [CrossRef] [PubMed]
- Gadd, G. Metals and microorganisms: A problem of definition. FEMS Microbiol. Lett. 1992, 100, 197–203. [Google Scholar] [CrossRef] [PubMed]
- Fomina, M.; Hillier, S.; Charnock, J.M.; Melville, K.; Alexander, I.J.; Gadd, G.M. Role of Oxalic Acid Overexcretion in Transformations of Toxic Metal Minerals by Beauveria caledonica. Appl. Environ. Microbiol. 2005, 71, 371–381. [Google Scholar] [CrossRef] [PubMed]
- Gadd, G.M. Interactions of fungip with toxic metals. New Phytol. 1993, 124, 25–60. [Google Scholar] [CrossRef]
- Brandl, H.; Faramarzi, M.A. Microbe-metal-interactions for the biotechnological treatment of metal-containing solid waste. China Particuol. 2006, 4, 93–97. [Google Scholar] [CrossRef]
- Rawlings, D.E.; Johnson, D.B. The microbiology of biomining: Development and optimization of mineral-oxidizing microbial consortia. Microbiology 2007, 153, 315–324. [Google Scholar] [CrossRef] [PubMed]
- Schippers, A.; Glombitza, F.; Sand, W. Geobiotechnology I. In Advances in Biochemical Engineering/Biotechnology; Springer: Berlin/Heidelberg, Germany, 2014; Volume 141, ISBN 978-3-642-54709-6. [Google Scholar]
- Torsvik, V.; Øvreås, L. Microbial diversity and function in soil: From genes to ecosystems. Curr. Opin. Microbiol. 2002, 5, 240–245. [Google Scholar] [CrossRef]
- Or, D.; Smets, B.F.; Wraith, J.M.; Dechesne, A.; Friedman, S.P. Physical constraints affecting bacterial habitats and activity in unsaturated porous media—A review. Adv. Water Resour. 2007, 30, 1505–1527. [Google Scholar] [CrossRef]
- Boer, W.; de Folman, L.B.; Summerbell, R.C.; Boddy, L. Living in a fungal world: Impact of fungi on soil bacterial niche development. FEMS Microbiol. Rev. 2005, 29, 795–811. [Google Scholar] [CrossRef] [PubMed]
- Dechesne, A.; Wang, G.; Gulez, G.; Or, D.; Smets, B.F. Hydration-controlled bacterial motility and dispersal on surfaces. Proc. Natl. Acad. Sci. USA 2010, 107, 14369–14372. [Google Scholar] [CrossRef] [PubMed]
- Harshey, R.M. Bacterial Motility on a Surface: Many Ways to a Common Goal. Annu. Rev. Microbiol. 2003, 57, 249–273. [Google Scholar] [CrossRef] [PubMed]
- Warmink, J.A.; Nazir, R.; Corten, B.; van Elsas, J.D. Hitchhikers on the fungal highway: The helper effect for bacterial migration via fungal hyphae. Soil Biol. Biochem. 2011, 43, 760–765. [Google Scholar] [CrossRef]
- Kershaw, M.J.; Talbot, N.J. Hydrophobins and Repellents: Proteins with Fundamental Roles in Fungal Morphogenesis. Fungal Genet. Biol. 1998, 23, 18–33. [Google Scholar] [CrossRef] [PubMed]
- Wösten, H.A.B. Hydrophobins: Multipurpose Proteins. Annu. Rev. Microbiol. 2001, 55, 625–646. [Google Scholar] [CrossRef] [PubMed]
- Klein, D.A.; Paschke, M.W. Filamentous Fungi: The Indeterminate Lifestyle and Microbial Ecology. Microb. Ecol. 2004, 47. [Google Scholar] [CrossRef] [PubMed]
- Boswell, G.P.; Jacobs, H.; Davidson, F.A.; Gadd, G.M.; Ritz, K. Functional Consequences of Nutrient Translocation in Mycelial Fungi. J. Theor. Biol. 2002, 217, 459–477. [Google Scholar] [CrossRef] [PubMed]
- Kohlmeier, S.; Smits, T.H.M.; Ford, R.M.; Keel, C.; Harms, H.; Wick, L.Y. Taking the fungal highway: Mobilization of pollutant-degrading bacteria by fungi. Environ. Sci. Technol. 2005, 39, 4640–4646. [Google Scholar] [CrossRef] [PubMed]
- Benedict, C.V.; Cameron, J.A.; Huang, S.J. Polycaprolactone degradation by mixed and pure cultures of bacteria and a yeast. J. Appl. Polym. Sci. 1983, 28, 335–342. [Google Scholar] [CrossRef]
- Senevirate, G.; Tennakoon, N.S.; Weerasekara, M.; Nandasena, K.A. Polyethylene Biodegradation by a Developed Penicillium-Bacillus Biofilm. Curr. Sci. 2006, 90, 20–21. [Google Scholar]
- Wick, L.Y.; Remer, R.; Würz, B.; Reichenbach, J.; Braun, S.; Schäfer, F.; Harms, H. Effect of Fungal Hyphae on the Access of Bacteria to Phenanthrene in Soil. Environ. Sci. Technol. 2007, 41, 500–505. [Google Scholar] [CrossRef] [PubMed]
- Worrich, A.; Stryhanyuk, H.; Musat, N.; König, S.; Banitz, T.; Centler, F.; Frank, K.; Thullner, M.; Harms, H.; Richnow, H.-H.; et al. Mycelium-mediated transfer of water and nutrients stimulates bacterial activity in dry and oligotrophic environments. Nat. Commun. 2017, 8, 15472. [Google Scholar] [CrossRef] [PubMed]
- Martin, G.; Guggiari, M.; Bravo, D.; Zopfi, J.; Cailleau, G.; Aragno, M.; Job, D.; Verrecchia, E.; Junier, P. Fungi, bacteria and soil pH: The oxalate-carbonate pathway as a model for metabolic interaction: Bacteria/fungi interactions and soil pH. Environ. Microbiol. 2012, 14, 2960–2970. [Google Scholar] [CrossRef] [PubMed]
- Kaya, M. Recovery of metals and nonmetals from electronic waste by physical and chemical recycling processes. Waste Manag. 2016, 57, 64–90. [Google Scholar] [CrossRef] [PubMed]
- Trevors, J.T.; Stratton, G.W.; Gadd, G.M. Cadmium transport, resistance, and toxicity in bacteria, algae, and fungi. Can. J. Microbiol. 1986, 32, 447–464. [Google Scholar] [CrossRef] [PubMed]
- Puckett, J.; Byster, L.; Westervelt, S.; Gutierrez, R.; Davis, S.; Hussain, A.; Dutta, M. Exporting Harm: The High-Tech Trashing of Asia; Basel Action Network: Seattle, WA, USA, 2002; Volume 3. [Google Scholar]
- Fernando, Q. Metal Speciation in Environmental and Biological Systems. Environ. Health Perspect. 1995, 103, 13. [Google Scholar] [CrossRef] [PubMed]
- Vig, K. Bioavailability and toxicity of cadmium to microorganisms and their activities in soil: A review. Adv. Environ. Res. 2003, 8, 121–135. [Google Scholar] [CrossRef]
- Ratte, H.T. Bioaccumulation and toxicity of silver compounds: A review. Environ. Toxicol. Chem. 1999, 18, 89–108. [Google Scholar] [CrossRef]
- Reith, F.; Lengke, M.F.; Falconer, D.; Craw, D.; Southam, G. The geomicrobiology of gold. ISME J. 2007, 1, 567–584. [Google Scholar] [CrossRef] [PubMed]
- Wu, C.; Luo, Y.; Deng, S.; Teng, Y.; Song, J. Spatial characteristics of cadmium in topsoils in a typical e-waste recycling area in southeast China and its potential threat to shallow groundwater. Sci. Total Environ. 2014, 472, 556–561. [Google Scholar] [CrossRef] [PubMed]
- Johnson, D.B. Biomining—Biotechnologies for extracting and recovering metals from ores and waste materials. Curr. Opin. Biotechnol. 2014, 30, 24–31. [Google Scholar] [CrossRef] [PubMed]
- Quezada-Hinojosa, R.P.; Föllmi, K.B.; Verrecchia, E.; Adatte, T.; Matera, V. Speciation and multivariable analyses of geogenic cadmium in soils at Le Gurnigel, Swiss Jura Mountains. CATENA 2015, 125, 10–32. [Google Scholar] [CrossRef]
- Federal Authorities of the Swiss Confederation RS 814.12 Ordonnance sur les Atteintes Portées aux Sols (OSol). Annexe 2, Valeurs Indicatives, Seuils d’Investigation et Valeurs d’Assainissement pour les Métaux Lourds et le Fluor Dans les Sols. Available online: https://www.admin.ch/opc/fr/classified-compilation/19981783/index.html (accessed on 15 January 2018).
- Simon, A.; Bindschedler, S.; Job, D.; Wick, L.Y.; Filippidou, S.; Kooli, W.M.; Verrecchia, E.P.; Junier, P. Exploiting the fungal highway: Development of a novel tool for the in situ isolation of bacteria migrating along fungal mycelium. FEMS Microbiol. Ecol. 2015, 91. [Google Scholar] [CrossRef] [PubMed]
- Altschul, S.F.; Gish, W.; Miller, W.; Myers, E.W.; Lipman, D.J. Basic local alignment search tool. J. Mol. Biol. 1990, 215, 403–410. [Google Scholar] [CrossRef]
- Gola, D.; Dey, P.; Bhattacharya, A.; Mishra, A.; Malik, A.; Namburath, M.; Ahammad, S.Z. Multiple heavy metal removal using an entomopathogenic fungi Beauveria bassiana. Bioresour. Technol. 2016, 218, 388–396. [Google Scholar] [CrossRef] [PubMed]
- Mohammadian Fazli, M.; Soleimani, N.; Mehrasbi, M.; Darabian, S.; Mohammadi, J.; Ramazani, A. Highly cadmium tolerant fungi: Their tolerance and removal potential. J. Environ. Health Sci. Eng. 2015, 13. [Google Scholar] [CrossRef] [PubMed]
- Bravo, D.; Cailleau, G.; Bindschedler, S.; Simon, A.; Job, D.; Verrecchia, E.; Junier, P. Isolation of oxalotrophic bacteria able to disperse on fungal mycelium. FEMS Microbiol. Lett. 2013, 348, 157–166. [Google Scholar] [CrossRef] [PubMed]
- Finlay, R.D. Ecological aspects of mycorrhizal symbiosis: With special emphasis on the functional diversity of interactions involving the extraradical mycelium. J. Exp. Bot. 2008, 59, 1115–1126. [Google Scholar] [CrossRef] [PubMed]
- Filippidou, S. Sporulation and Metabolism of Endospore-Forming Firmicutes under Conditions Limiting for Growth and Survival. Available online: https://explore.rero.ch/fr_CH/nj/result/L/VlRMU19SRVJPUjAwODQzMDM5MQ== (accessed on 17 January 2018).
- Angle, J.S.; McGrath, S.P.; Chaney, R.L. New Culture Medium Containing Ionic Concentrations of Nutrients Similar to Concentrations Found in the Soil Solution. Appl. Environ. Microbiol. 1991, 57, 3674–3676. [Google Scholar] [PubMed]
- Miquel Guennoc, C.; Rose, C.; Guinnet, F.; Miquel, I.; Labbé, J.; Deveau, A. A New Method for Qualitative Multi-scale Analysis of Bacterial Biofilms on Filamentous Fungal Colonies Using Confocal and Electron Microscopy. J. Vis. Exp. 2017, 119. [Google Scholar] [CrossRef] [PubMed]
- Dykstra, M.J.; Reuss, L.E. Biological Electron Microscopy: Theory, Techniques, and Troubleshooting, 2nd ed.; Kluwer Academic/Plenum Publishers: New York, NY, USA, 2003; ISBN 978-0-306-47749-2. [Google Scholar]
- Congeevaram, S.; Dhanarani, S.; Park, J.; Dexilin, M.; Thamaraiselvi, K. Biosorption of chromium and nickel by heavy metal resistant fungal and bacterial isolates. J. Hazard. Mater. 2007, 146, 270–277. [Google Scholar] [CrossRef] [PubMed]
- Egerton-Warburton, L.M.; Griffin, B.J. Differential responses of Pisolithus tinctorius isolates to aluminum in vitro. Can. J. Bot. 1995, 73, 1229–1233. [Google Scholar] [CrossRef]
- Long, J.; Li, H.; Jiang, D.; Luo, D.; Chen, Y.; Xia, J.; Chen, D. Biosorption of strontium(II) from aqueous solutions by Bacillus cereus isolated from strontium hyperaccumulator Andropogon gayanus. Process Saf. Environ. Prot. 2017, 111, 23–30. [Google Scholar] [CrossRef]
- Nongmaithem, N.; Roy, A.; Bhattacharya, P.M. Screening of Trichoderma isolates for their potential of biosorption of nickel and cadmium. Braz. J. Microbiol. 2016, 47, 305–313. [Google Scholar] [CrossRef] [PubMed]
- Zouboulis, A.; Loukidou, M.; Matis, K. Biosorption of toxic metals from aqueous solutions by bacteria strains isolated from metal-polluted soils. Process Biochem. 2004, 39, 909–916. [Google Scholar] [CrossRef]
- Horiike, T.; Yamashita, M. A New Fungal Isolate, Penidiella sp. Strain T9, Accumulates the Rare Earth Element Dysprosium. Appl. Environ. Microbiol. 2015, 81, 3062–3068. [Google Scholar] [CrossRef] [PubMed]
- Blaudez, D.; Jacob, C.; Turnau, K.; Colpaert, J.V.; Ahonen-Jonnarth, U.; Finlay, R.; Botton, B.; Chalot, M. Differential responses of ectomycorrhizal fungi to heavy metals in vitro. Mycol. Res. 2000, 104, 1366–1371. [Google Scholar] [CrossRef]
- Jones, M.D.; Hutchinson, T.C. The effects of nickel and copper on the axenic growth of ectomycorrhizal fungi. Can. J. Bot. 1988, 66, 119–124. [Google Scholar] [CrossRef]
- Ledin, M. Accumulation of metals by microorganisms—Processes and importance for soil systems. Earth-Sci. Rev. 2000, 51, 1–31. [Google Scholar] [CrossRef]
- Ellis, R.J.; Morgan, P.; Weightman, A.J.; Fry, J.C. Cultivation-dependent and -independent approaches for determining bacterial diversity in heavy-metal-contaminated soil. Appl. Environ. Microbiol. 2003, 69, 3223–3230. [Google Scholar] [CrossRef] [PubMed]
- Ramsay, L.; Sayer, J.; Gadd, G.; Gow, N.; Robson, G. Stress responses of fungal colonies towards toxic metals. In The Fungal Colony; Cambridge University Press: Cambridge, UK, 1999; pp. 178–200. [Google Scholar]
- Pradhan, S.; Singh, S.; Rai, L.C. Characterization of various functional groups present in the capsule of Microcystis and study of their role in biosorption of Fe, Ni and Cr. Bioresour. Technol. 2007, 98, 595–601. [Google Scholar] [CrossRef] [PubMed]
- Volesky, B. Biosorption and me. Water Res. 2007, 41, 4017–4029. [Google Scholar] [CrossRef] [PubMed]
- Shuttleworth, K.L.; Unz, R.F. Sorption of heavy metals to the filamentous bacterium Thiothrix strain A1. Appl. Environ. Microbiol. 1993, 59, 1274–1282. [Google Scholar] [PubMed]
- Hughes, M.N.; Poole, R.K. Metal speciation and microbial growth—The hard (and soft) facts. J. Gen. Microbiol. 1991, 137, 725–734. [Google Scholar] [CrossRef]
- Kumari, D.; Qian, X.-Y.; Pan, X.; Achal, V.; Li, Q.; Gadd, G.M. Microbially-Induced Carbonate Precipitation for Immobilization of Toxic Metals. In Advances in Applied Microbiology; Elsevier: Amsterdam, The Netherlands, 2016; Volume 94, pp. 79–108. ISBN 978-0-12-804803-0. [Google Scholar]
- Li, Q.; Csetenyi, L.; Paton, G.I.; Gadd, G.M. CaCO3 and SrCO3 bioprecipitation by fungi isolated from calcareous soil: Metal carbonate biomineralization by fungi. Environ. Microbiol. 2015, 17, 3082–3097. [Google Scholar] [CrossRef] [PubMed]
- Li, Q.; Csetenyi, L.; Gadd, G.M. Biomineralization of Metal Carbonates by Neurospora crassa. Environ. Sci. Technol. 2014, 48, 14409–14416. [Google Scholar] [CrossRef] [PubMed]
- Fogarty, R.V.; Tobin, J.M. Fungal melanins and their interactions with metals. Enzyme Microb. Technol. 1996, 19, 311–317. [Google Scholar] [CrossRef]
- Purvis, O.W.; Bailey, E.H.; McLean, J.; Kasama, T.; Williamson, B.J. Uranium Biosorption by the Lichen Trapelia involuta at a Uranium Mine. Geomicrobiol. J. 2004, 21, 159–167. [Google Scholar] [CrossRef]
- Fomina, M.; Gadd, G.M. Metal sorption by biomass of melanin-producing fungi grown in clay-containing medium. J. Chem. Technol. Biotechnol. 2003, 78, 23–34. [Google Scholar] [CrossRef]
- Pons, M.P.; Fusté, M.C. Uranium uptake by immobilized cells of Pseudomonas strain EPS 5028. Appl. Microbiol. Biotechnol. 1993, 39, 661–665. [Google Scholar] [CrossRef]
- De Rome, L.; Gadd, G.M. Use of pelleted and immobilized yeast and fungal biomass for heavy metal and radionuclide recovery. J. Ind. Microbiol. 1991, 7, 97–104. [Google Scholar] [CrossRef]

| 0.05 mM Cd “j” FH Columns | Fungi | Bacteria | Couple Name | 0.1 mM Cd “b” FH Columns | Fungi | Bacteria | 0 mM Cd “r” FH Columns | Fungi | Bacteria | |
|---|---|---|---|---|---|---|---|---|---|---|
| Site 1 (Low Cd) | j1 | + | + | 1j1 | b1 | - | - | r1 | + | + |
| j2 | + | + | 1j2 | b2 | - | - | ||||
| j3 | - | - | b3 | - | - | |||||
| Site 2 (Middle Cd) | j1 | + | + | 2j1 | b1 | - | - | r1 | + | + |
| j2 | + | + | 2j2 | b2 | - | - | ||||
| j3 | + | + | 2j3 | b3 | - | - | ||||
| j4 | + | + | 2j4 | b4 | - | - | ||||
| Site 3 (High Cd) | j1 | - | - | b1 | - | - | r1 | + | + | |
| j2 | - | - | b2 | - | - | |||||
| j3 | - | - | b3 | - | - | |||||
| j4 | - | - | b4 | - | - | r2 | + | + | ||
| j5 | - | - | b5 | - | ||||||
| j6 | - | - | b6 | - | - | |||||
| j7 | + | + | 2j7 | b7 | ND | ND |
| Criteria | ||||||
|---|---|---|---|---|---|---|
| BF Couple | (1) Cd Tolerance | (2) Bacterial Inhibition on Fungus | (3) Physical Contact | (4) FH | Synergistic BF Couple | |
| Isolates FH columns | 1j1 | 0.25 mM | Yes | No | No | No |
| 1j2 | 0.25 mM | Yes | No | No | No | |
| 2j1 | 0.25 mM | No | No | No | No | |
| 2j2 | 0.25 mM | Yes | No | No | No | |
| 2j3 | 0.1 mM | No | No | No | No | |
| 2j4 | 0.25 mM | No | No | No | No | |
| 3j7 | 1 mM | Until 0.25 mM Cd | Yes | Until 0.5 mM Cd | Yes | |
| Strains culture collection | Be. brongniartii–S. ureilytica Lr 5/4 | 1 mM | Yes | No | No | No |
| L. bicolor–S. ureilytica Lr 5/4 | 0.25 mM | Yes | No | No | No | |
| A. mellea–S. ureilytica Lr 5/4 | - | Yes | No | No | No | |
| T. rossicum–Serratia ureilytica Lr 5/4 | 1 mM | In 0 mM Cd | Yes | Yes | Yes | |
| Bacterial-Fungal Couple | Cd Concentration (mM) | Presence of Fungus behind Gap | Presence of Bacteria behind Gap | Alkalinization of Urea Medium |
|---|---|---|---|---|
| B. exigua–Peusdomonas sp. | 0 | Yes | No | Yes |
| 0.1 | Yes | No | Yes | |
| 0.25 | Yes | No | Yes | |
| 0.5 | No | No | No | |
| 0.75 | No | No | No | |
| 1 | No | No | No | |
| T. rossicum–S. ureilytica Lr 5/4 | 0 | Yes | Yes | Yes |
| 0.1 | Yes | Yes | Yes | |
| 0.25 | Yes | Yes | Yes | |
| 0.5 | Yes | Yes | Yes | |
| 0.75 | Yes | No | Yes | |
| 1 | No | No | No |
© 2018 by the authors. Licensee MDPI, Basel, Switzerland. This article is an open access article distributed under the terms and conditions of the Creative Commons Attribution (CC BY) license (http://creativecommons.org/licenses/by/4.0/).
Share and Cite
Losa, G.; Bindschedler, S. Enhanced Tolerance to Cadmium in Bacterial-Fungal Co-Cultures as a Strategy for Metal Biorecovery from e-Waste. Minerals 2018, 8, 121. https://doi.org/10.3390/min8040121
Losa G, Bindschedler S. Enhanced Tolerance to Cadmium in Bacterial-Fungal Co-Cultures as a Strategy for Metal Biorecovery from e-Waste. Minerals. 2018; 8(4):121. https://doi.org/10.3390/min8040121
Chicago/Turabian StyleLosa, Geremia, and Saskia Bindschedler. 2018. "Enhanced Tolerance to Cadmium in Bacterial-Fungal Co-Cultures as a Strategy for Metal Biorecovery from e-Waste" Minerals 8, no. 4: 121. https://doi.org/10.3390/min8040121
APA StyleLosa, G., & Bindschedler, S. (2018). Enhanced Tolerance to Cadmium in Bacterial-Fungal Co-Cultures as a Strategy for Metal Biorecovery from e-Waste. Minerals, 8(4), 121. https://doi.org/10.3390/min8040121
